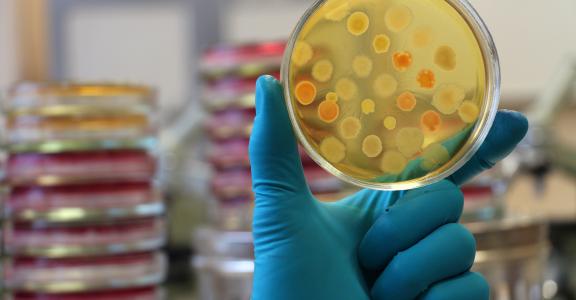
Gloved hand of laboratory technician holding a petri dish.

Step into real research—one phage at a time
Step into the world of real scientific discovery through the study of bacteriophages—viruses that infect bacteria. In this hands-on, project-based course, you’ll learn how to design and carry out hypothesis-driven research while exploring the structure and genome of your own unique phage.
Working in a lab, you’ll isolate and characterize bacteriophages that infect mycobacterium, a harmless soil bacterium related to the one that causes tuberculosis. Along the way, you’ll practice essential lab skills such as sterile technique, solution preparation, DNA manipulation, and bioinformatic genome analysis.
Phage hunting combines art, science, and adventure—you’ll collect samples from the environment, investigate how phages interact with their bacterial hosts, and uncover the secrets hidden in their genetic code. By the end of the course, your discoveries will contribute to a growing scientific database that helps researchers better understand phage diversity, bacterial genetics, and even tuberculosis biology.